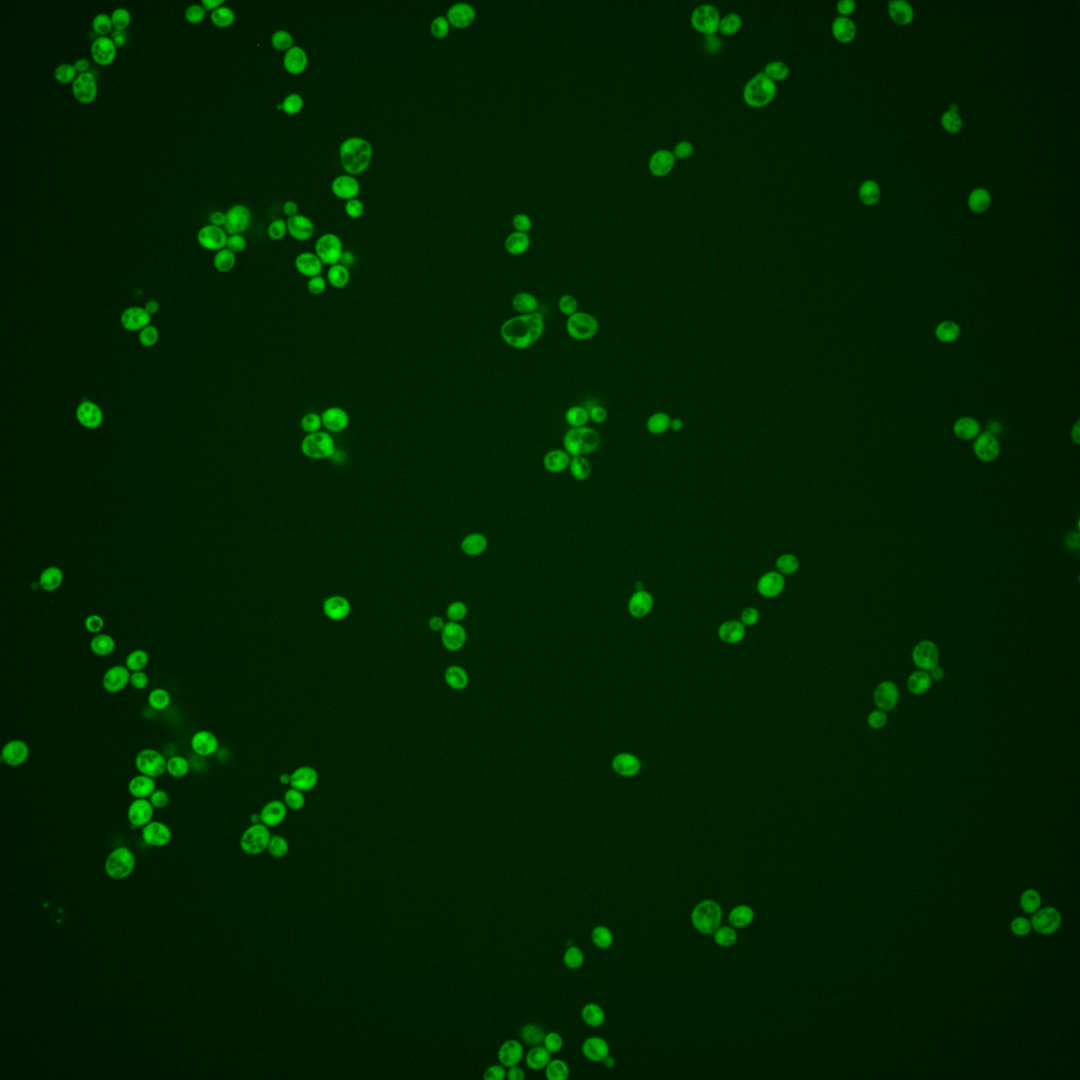
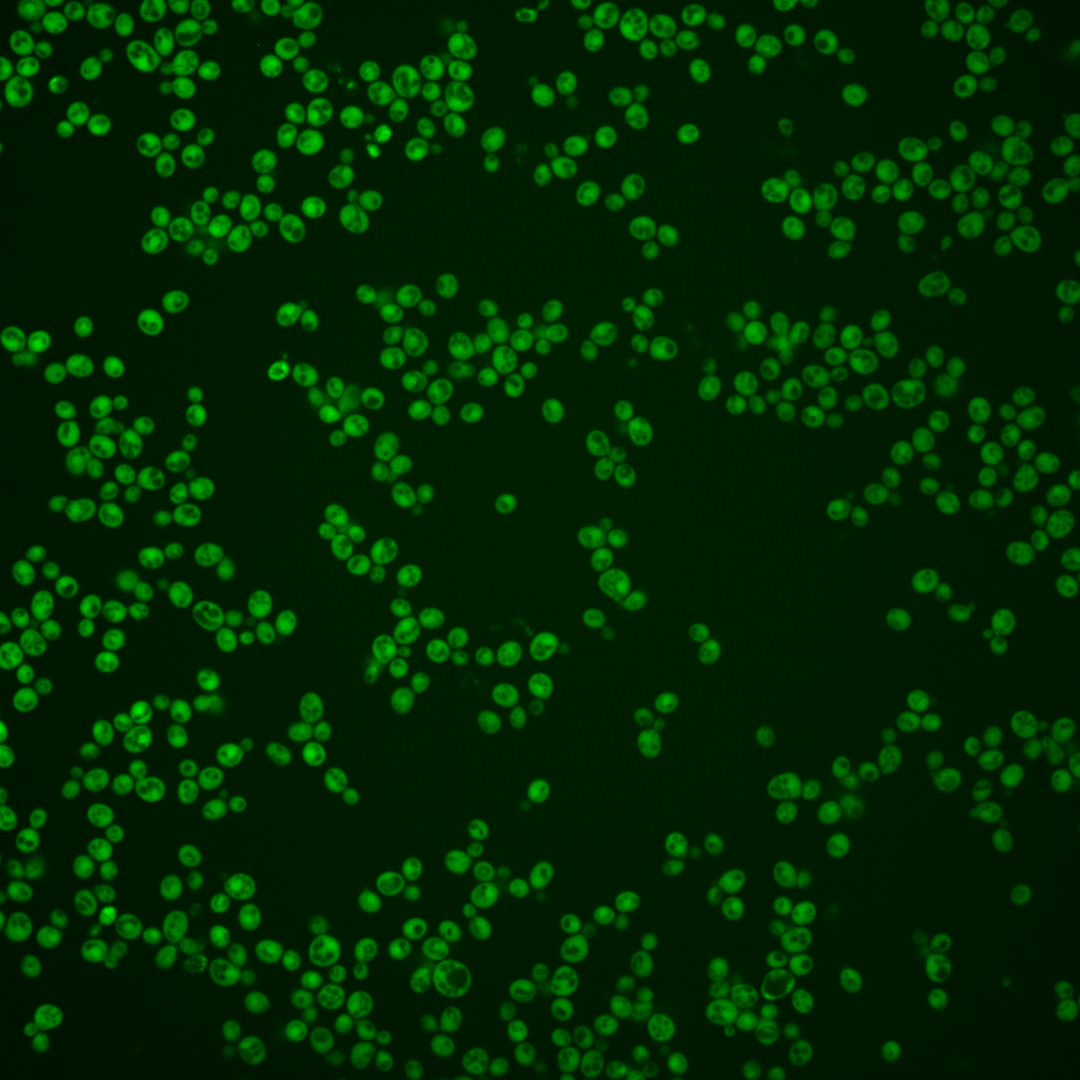
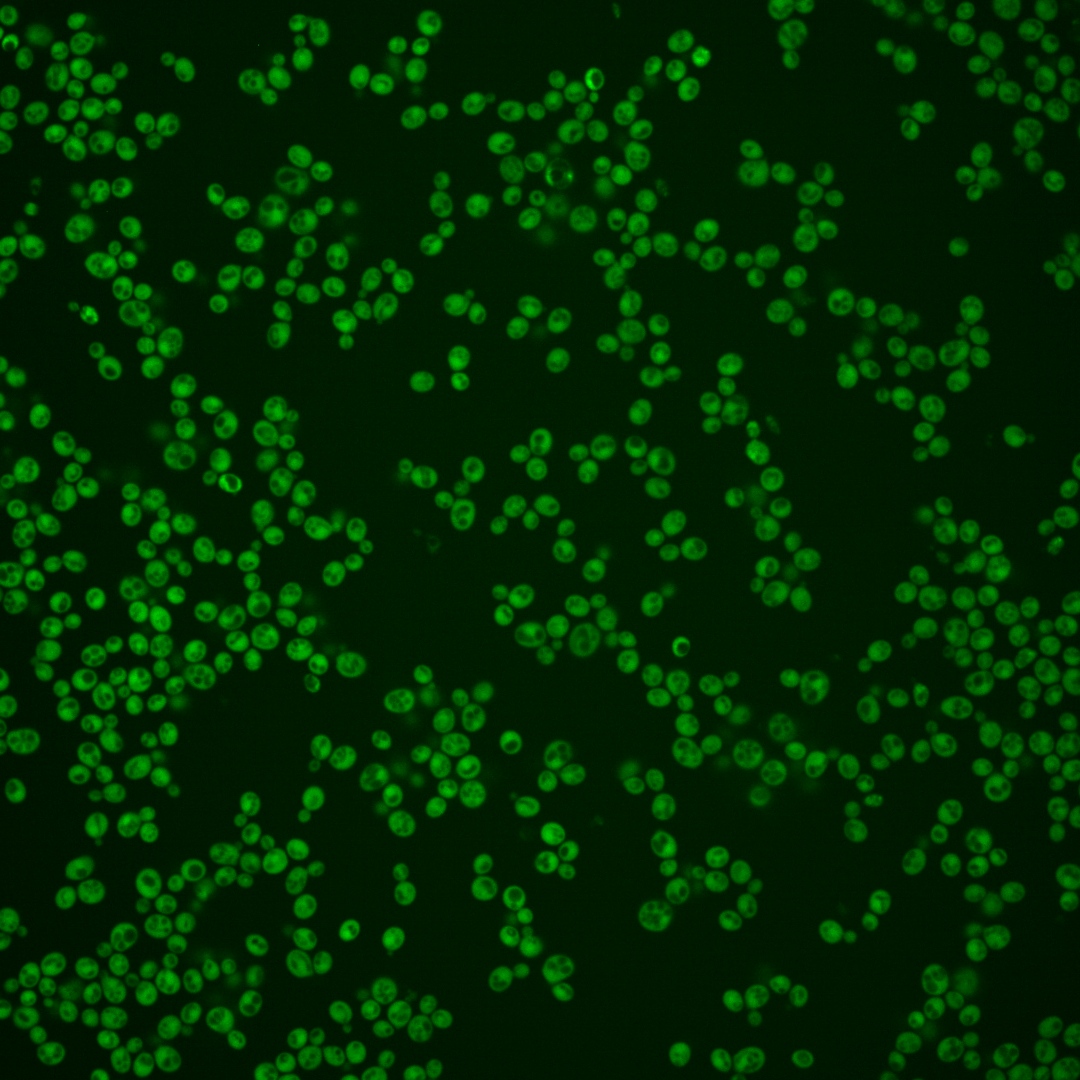
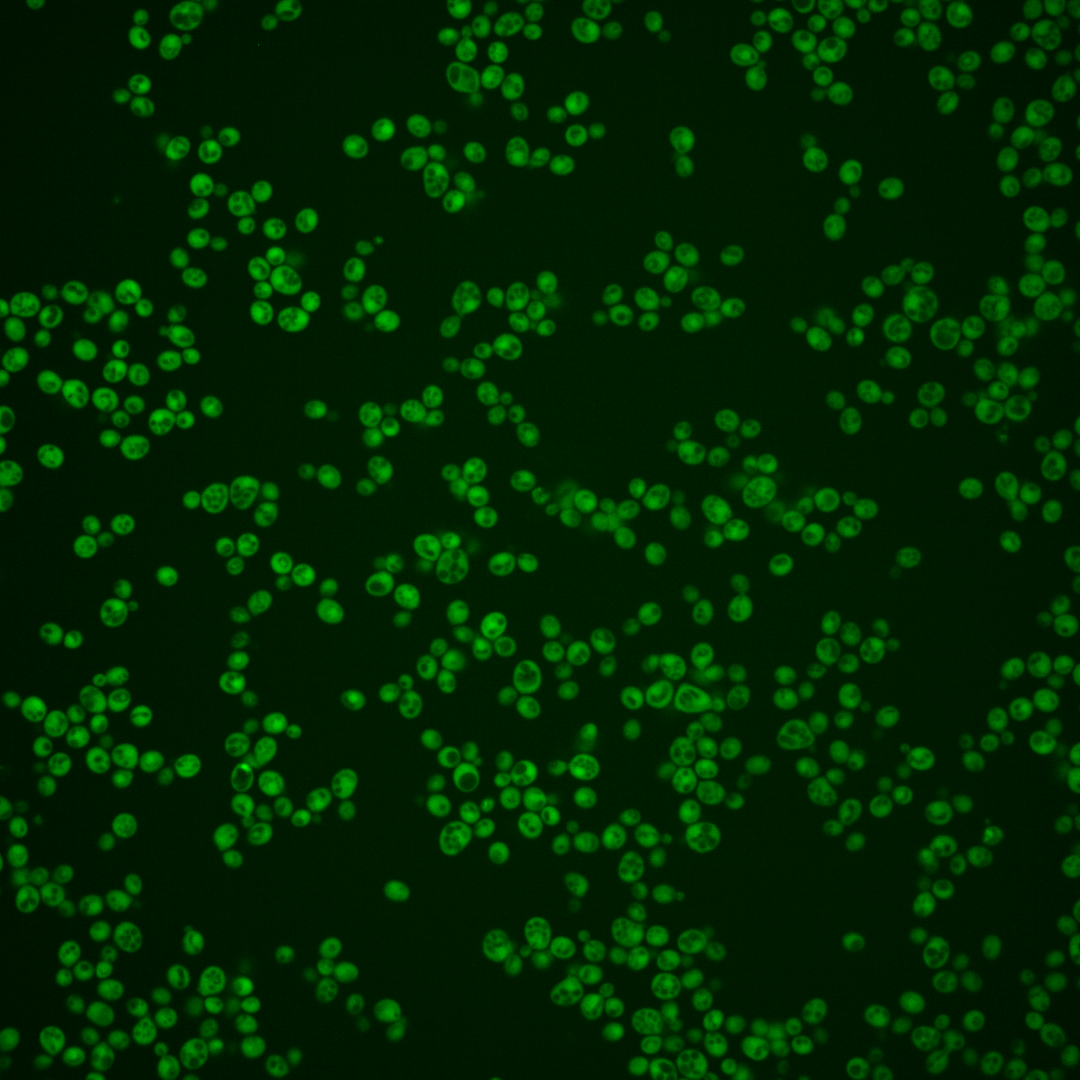

| Standard name | |
|---|---|
| Human Ortholog | |
| Description | Protein with a possible role in tRNA export; shows similarity to 6-phosphogluconolactonase non-catalytic domains but does not exhibit this enzymatic activity; homologous to Sol3p and Sol4p; SOL1 has a paralog, SOL2, that arose from the whole genome duplication; protein abundance increases in response to DNA replication stress |
Micrographs




















































































Sub-cellular Localization
Yeast GFP Assignment
Protein Abundance
Localization Change
External localization resources
| ensLOC | DeepLoc | |||||||||||||||||||||||
|---|---|---|---|---|---|---|---|---|---|---|---|---|---|---|---|---|---|---|---|---|---|---|---|---|
| Localization | WT1 | WT2 | WT3 | RAP60 | RAP140 | RAP220 | RAP300 | RAP380 | RAP460 | RAP540 | RAP620 | RAP700 | HU80 | HU120 | HU160 | rpd3Δ_1 | rpd3Δ_2 | rpd3Δ_3 | WT1 | WT2 | WT3 | AF100 | AF140 | AF180 |
| Cortical Patches | 0 | 0 | 0 | 0 | 0 | 1 | 0 | 0 | 0 | 0 | 0 | 0 | 0 | 0 | 0 | 0 | 0 | 0 | 0 | 0 | 1 | 0 | 1 | 0 |
| Bud | 0 | 0 | 0 | 0 | 2 | 1 | 0 | 3 | 3 | 6 | 4 | 7 | 0 | 0 | 0 | 0 | 0 | 0 | 1 | 1 | 0 | 0 | 3 | 0 |
| Bud Neck | 0 | 0 | 0 | 0 | 0 | 0 | 0 | 0 | 0 | 0 | 0 | 0 | 0 | 0 | 0 | 0 | 0 | 0 | 0 | 0 | 0 | 0 | 0 | 1 |
| Bud Site | 0 | 0 | 0 | 0 | 0 | 0 | 0 | 0 | 0 | 0 | 1 | 0 | 0 | 0 | 0 | 0 | 0 | 0 | – | – | – | – | – | – |
| Cell Periphery | 0 | 3 | 4 | 0 | 2 | 3 | 3 | 4 | 3 | 7 | 5 | 8 | 1 | 3 | 0 | 12 | 18 | 17 | 0 | 0 | 0 | 0 | 0 | 0 |
| Cytoplasm | 313 | 248 | 248 | 279 | 391 | 369 | 323 | 406 | 313 | 289 | 224 | 291 | 278 | 370 | 365 | 239 | 323 | 232 | 309 | 224 | 241 | 169 | 315 | 299 |
| Endoplasmic Reticulum | 1 | 3 | 2 | 1 | 2 | 3 | 4 | 2 | 1 | 1 | 0 | 3 | 2 | 0 | 1 | 4 | 10 | 9 | 0 | 0 | 0 | 0 | 3 | 2 |
| Endosome | 0 | 0 | 0 | 0 | 0 | 0 | 1 | 0 | 0 | 0 | 0 | 0 | 2 | 0 | 1 | 0 | 0 | 0 | 1 | 0 | 0 | 1 | 1 | 0 |
| Golgi | 0 | 0 | 0 | 0 | 0 | 0 | 0 | 0 | 0 | 0 | 0 | 0 | 0 | 0 | 0 | 1 | 1 | 1 | 0 | 0 | 0 | 0 | 1 | 0 |
| Mitochondria | 1 | 0 | 0 | 3 | 1 | 14 | 36 | 39 | 84 | 51 | 100 | 62 | 0 | 0 | 0 | 0 | 1 | 1 | 1 | 1 | 3 | 0 | 0 | 1 |
| Nucleus | 2 | 7 | 4 | 3 | 2 | 5 | 5 | 12 | 5 | 10 | 4 | 12 | 2 | 3 | 5 | 6 | 5 | 3 | 0 | 7 | 3 | 2 | 3 | 0 |
| Nuclear Periphery | 0 | 0 | 0 | 0 | 0 | 0 | 0 | 3 | 1 | 0 | 0 | 0 | 0 | 0 | 0 | 0 | 0 | 0 | 0 | 0 | 0 | 0 | 0 | 0 |
| Nucleolus | 0 | 0 | 0 | 1 | 0 | 0 | 0 | 0 | 0 | 0 | 0 | 0 | 0 | 0 | 0 | 0 | 0 | 0 | 0 | 0 | 0 | 0 | 0 | 0 |
| Peroxisomes | 0 | 0 | 0 | 0 | 0 | 0 | 0 | 0 | 0 | 0 | 0 | 0 | 0 | 0 | 0 | 0 | 0 | 0 | 0 | 0 | 0 | 0 | 0 | 0 |
| SpindlePole | 0 | 0 | 0 | 0 | 0 | 0 | 0 | 1 | 0 | 0 | 0 | 0 | 0 | 0 | 0 | 0 | 0 | 0 | 0 | 0 | 0 | 0 | 1 | 0 |
| Vac/Vac Membrane | 1 | 0 | 6 | 15 | 16 | 16 | 19 | 51 | 33 | 60 | 22 | 48 | 2 | 3 | 1 | 17 | 14 | 8 | 0 | 11 | 1 | 0 | 3 | 1 |
| Unique Cell Count | 315 | 252 | 255 | 291 | 407 | 396 | 374 | 496 | 393 | 379 | 312 | 390 | 284 | 373 | 367 | 258 | 346 | 242 | 319 | 250 | 255 | 179 | 338 | 311 |
| Labelled Cell Count | 318 | 261 | 264 | 302 | 416 | 412 | 391 | 521 | 443 | 424 | 360 | 431 | 287 | 379 | 373 | 279 | 372 | 271 | 319 | 250 | 255 | 179 | 338 | 311 |
Yeast GFP Assignment
Protein Abundance
| Screen | WT1 | WT2 | WT3 | RAP60 | RAP140 | RAP220 | RAP300 | RAP380 | RAP460 | RAP540 | RAP620 | RAP700 | HU80 | HU120 | HU160 | rpd3Δ_1 | rpd3Δ_2 | rpd3Δ_3 | AF100 | AF140 | AF180 |
|---|---|---|---|---|---|---|---|---|---|---|---|---|---|---|---|---|---|---|---|---|---|
| Mean Cell GFP Intensity (1e-4) | 10.0 | 14.0 | 10.6 | 9.7 | 9.3 | 7.8 | 7.1 | 7.5 | 6.3 | 6.7 | 6.0 | 6.7 | 11.0 | 12.5 | 12.6 | 22.9 | 22.7 | 23.0 | 11.2 | 11.8 | 13.0 |
| Std Deviation (1e-4) | 1.7 | 2.6 | 1.3 | 1.4 | 1.4 | 1.5 | 1.4 | 1.4 | 1.3 | 1.5 | 1.3 | 1.5 | 1.9 | 2.3 | 1.9 | 6.2 | 7.1 | 6.1 | 1.9 | 2.1 | 2.3 |
| Intensity Change (Log2) | – | – | – | -0.13 | -0.18 | -0.45 | -0.58 | -0.5 | -0.74 | -0.65 | -0.82 | -0.65 | 0.06 | 0.25 | 0.25 | 1.11 | 1.1 | 1.12 | 0.08 | 0.16 | 0.3 |
Localization Change
| Localization | RAP60 | RAP140 | RAP220 | RAP300 | RAP380 | RAP460 | RAP540 | RAP620 | RAP700 | HU80 | HU120 | HU160 | rpd3Δ_1 | rpd3Δ_2 | rpd3Δ_3 |
|---|---|---|---|---|---|---|---|---|---|---|---|---|---|---|---|
| Cortical Patches | 0 | 0 | 0 | 0 | 0 | 0 | 0 | 0 | 0 | 0 | 0 | 0 | 0 | 0 | 0 |
| Bud | 0 | 0 | 0 | 0 | 0 | 0 | 0 | 0 | 0 | 0 | 0 | 0 | 0 | 0 | 0 |
| Bud Neck | 0 | 0 | 0 | 0 | 0 | 0 | 0 | 0 | 0 | 0 | 0 | 0 | 0 | 0 | 0 |
| Bud Site | 0 | 0 | 0 | 0 | 0 | 0 | 0 | 0 | 0 | 0 | 0 | 0 | 0 | 0 | 0 |
| Cell Periphery | 0 | 0 | 0 | 0 | 0 | 0 | 0 | 0 | 0 | 0 | 0 | 0 | 2.0 | 2.3 | 3.0 |
| Cytoplasm | -0.9 | -0.8 | -2.3 | -4.6 | -6.0 | -6.4 | -7.2 | -8.1 | -7.6 | 0.5 | 1.9 | 2.3 | -2.4 | -2.2 | -0.9 |
| Endoplasmic Reticulum | 0 | 0 | 0 | 0 | 0 | 0 | 0 | 0 | 0 | 0 | 0 | 0 | 0 | 1.8 | 2.2 |
| Endosome | 0 | 0 | 0 | 0 | 0 | 0 | 0 | 0 | 0 | 0 | 0 | 0 | 0 | 0 | 0 |
| Golgi | 0 | 0 | 0 | 0 | 0 | 0 | 0 | 0 | 0 | 0 | 0 | 0 | 0 | 0 | 0 |
| Mitochondria | 0 | 0 | 3.0 | 5.1 | 4.6 | 7.9 | 6.1 | 10.0 | 6.7 | 0 | 0 | 0 | 0 | 0 | 0 |
| Nucleus | 0 | 0 | 0 | 0 | 0.8 | 0 | 0.9 | 0 | 1.2 | 0 | 0 | 0 | 0 | 0 | 0 |
| Nuclear Periphery | 0 | 0 | 0 | 0 | 0 | 0 | 0 | 0 | 0 | 0 | 0 | 0 | 0 | 0 | 0 |
| Nucleolus | 0 | 0 | 0 | 0 | 0 | 0 | 0 | 0 | 0 | 0 | 0 | 0 | 0 | 0 | 0 |
| Peroxisomes | 0 | 0 | 0 | 0 | 0 | 0 | 0 | 0 | 0 | 0 | 0 | 0 | 0 | 0 | 0 |
| SpindlePole | 0 | 0 | 0 | 0 | 0 | 0 | 0 | 0 | 0 | 0 | 0 | 0 | 0 | 0 | 0 |
| Vacuole | 1.7 | 1.1 | 1.2 | 1.7 | 3.9 | 3.2 | 5.4 | 2.6 | 4.5 | 0 | 0 | 0 | 2.3 | 1.1 | 0.6 |
External localization resources
Images






























Protein Concentration and Protein Localization Data
| R1 | R2 | R3 | ||||||||||||||||
|---|---|---|---|---|---|---|---|---|---|---|---|---|---|---|---|---|---|---|
| G1 Pre-START | G1 Post-START | S/G2 | Metaphase | Anaphase | Telophase | G1 Pre-START | G1 Post-START | S/G2 | Metaphase | Anaphase | Telophase | G1 Pre-START | G1 Post-START | S/G2 | Metaphase | Anaphase | Telophase | |
| Concentration | 7.9371 | 9.5951 | 8.5544 | 7.9827 | 8.4729 | 8.265 | 9.1589 | 10.4552 | 9.7842 | 7.7261 | 8.7568 | 9.2842 | 9.6004 | 11.3403 | 10.3981 | 10.6921 | 9.7479 | 10.525 |
| Actin | 0.0066 | 0.001 | 0.002 | 0.0003 | 0.0005 | 0.0064 | 0.0042 | 0.0003 | 0.0014 | 0.0004 | 0.0001 | 0.0007 | 0.0085 | 0.0007 | 0.0003 | 0.0003 | 0.0002 | 0.0007 |
| Bud | 0.0044 | 0.0036 | 0.0002 | 0.0004 | 0.0275 | 0.0007 | 0.0028 | 0.0024 | 0.0007 | 0.0002 | 0 | 0.0005 | 0.003 | 0.0044 | 0.0001 | 0.0007 | 0.0001 | 0.0002 |
| Bud Neck | 0.0007 | 0.0004 | 0.0005 | 0.0011 | 0.0019 | 0.0016 | 0.0017 | 0.0002 | 0.0006 | 0.0008 | 0.001 | 0.0016 | 0.0005 | 0.0002 | 0.0004 | 0.0004 | 0.0005 | 0.001 |
| Bud Periphery | 0.0018 | 0.0007 | 0.0001 | 0.0001 | 0.0038 | 0.0002 | 0.0009 | 0.0003 | 0.0003 | 0 | 0 | 0.0001 | 0.0005 | 0.0004 | 0 | 0.0001 | 0 | 0 |
| Bud Site | 0.0028 | 0.0073 | 0.0006 | 0.0002 | 0.002 | 0.0004 | 0.0067 | 0.0004 | 0.0005 | 0.0001 | 0 | 0.0001 | 0.0014 | 0.005 | 0.0001 | 0.0002 | 0 | 0.0001 |
| Cell Periphery | 0.0004 | 0.0001 | 0 | 0 | 0.0001 | 0 | 0.0001 | 0 | 0 | 0 | 0 | 0 | 0.0001 | 0.0001 | 0 | 0 | 0 | 0 |
| Cytoplasm | 0.8846 | 0.9353 | 0.9418 | 0.8954 | 0.8421 | 0.9134 | 0.9086 | 0.9763 | 0.9692 | 0.9512 | 0.9611 | 0.939 | 0.915 | 0.96 | 0.9677 | 0.911 | 0.8995 | 0.9471 |
| Cytoplasmic Foci | 0.0099 | 0.0044 | 0.0048 | 0.0076 | 0.0194 | 0.0063 | 0.0044 | 0.0014 | 0.0038 | 0.0059 | 0.0015 | 0.0051 | 0.0102 | 0.0024 | 0.0013 | 0.0222 | 0.0013 | 0.0028 |
| Eisosomes | 0.0004 | 0 | 0 | 0 | 0 | 0.0001 | 0 | 0 | 0 | 0 | 0 | 0 | 0 | 0 | 0 | 0 | 0 | 0 |
| Endoplasmic Reticulum | 0.0036 | 0.0012 | 0.0019 | 0.0024 | 0.0022 | 0.0026 | 0.0074 | 0.0009 | 0.0013 | 0.0015 | 0.0015 | 0.0019 | 0.003 | 0.0011 | 0.0011 | 0.001 | 0.004 | 0.0029 |
| Endosome | 0.01 | 0.0016 | 0.0052 | 0.0023 | 0.0044 | 0.0075 | 0.0135 | 0.0006 | 0.0008 | 0.0015 | 0.0005 | 0.0019 | 0.0042 | 0.001 | 0.0004 | 0.0005 | 0.0016 | 0.0021 |
| Golgi | 0.0019 | 0.0001 | 0.0009 | 0.0001 | 0.0003 | 0.0013 | 0.0012 | 0 | 0.0001 | 0.0001 | 0 | 0.0001 | 0.0007 | 0.0001 | 0 | 0.0001 | 0 | 0.0001 |
| Lipid Particles | 0.0043 | 0.0001 | 0.0002 | 0 | 0.0001 | 0.0023 | 0.0024 | 0 | 0.0001 | 0 | 0 | 0 | 0.0006 | 0.0001 | 0 | 0.0003 | 0 | 0 |
| Mitochondria | 0.0044 | 0.0003 | 0.0012 | 0.0003 | 0.0004 | 0.0006 | 0.0006 | 0.0001 | 0.0001 | 0.0002 | 0.0001 | 0.0002 | 0.0007 | 0.0004 | 0.0001 | 0.001 | 0.0002 | 0.0002 |
| None | 0.0101 | 0.0032 | 0.0025 | 0.0031 | 0.0035 | 0.0038 | 0.006 | 0.0019 | 0.002 | 0.0035 | 0.0023 | 0.0042 | 0.004 | 0.0013 | 0.0011 | 0.0081 | 0.0012 | 0.0015 |
| Nuclear Periphery | 0.0096 | 0.0037 | 0.004 | 0.0063 | 0.0048 | 0.0053 | 0.0109 | 0.0013 | 0.0016 | 0.0032 | 0.0019 | 0.003 | 0.0054 | 0.0022 | 0.0032 | 0.0058 | 0.0181 | 0.0051 |
| Nucleolus | 0.0026 | 0.0002 | 0 | 0.0001 | 0.0008 | 0.0002 | 0.0002 | 0 | 0 | 0 | 0 | 0.0001 | 0.0001 | 0.0009 | 0 | 0.0015 | 0 | 0 |
| Nucleus | 0.0303 | 0.0323 | 0.0312 | 0.074 | 0.0681 | 0.0409 | 0.0237 | 0.0129 | 0.0157 | 0.0292 | 0.0288 | 0.0373 | 0.0379 | 0.0172 | 0.0229 | 0.0373 | 0.0708 | 0.034 |
| Peroxisomes | 0.0042 | 0.0001 | 0.0005 | 0.0002 | 0.0003 | 0.0007 | 0.0005 | 0 | 0.0001 | 0.0001 | 0 | 0.0001 | 0.0008 | 0.0001 | 0 | 0.0002 | 0 | 0.0001 |
| Punctate Nuclear | 0.0048 | 0.0031 | 0.0012 | 0.0046 | 0.0158 | 0.0042 | 0.0024 | 0.0005 | 0.0014 | 0.0011 | 0.0008 | 0.003 | 0.0022 | 0.0017 | 0.0007 | 0.0081 | 0.001 | 0.0012 |
| Vacuole | 0.0019 | 0.0011 | 0.0008 | 0.0013 | 0.0015 | 0.0014 | 0.0013 | 0.0004 | 0.0003 | 0.0007 | 0.0003 | 0.0007 | 0.0009 | 0.0005 | 0.0004 | 0.0009 | 0.0009 | 0.0007 |
| Vacuole Periphery | 0.0007 | 0.0002 | 0.0002 | 0.0003 | 0.0003 | 0.0004 | 0.0004 | 0.0001 | 0.0001 | 0.0001 | 0.0001 | 0.0001 | 0.0002 | 0.0001 | 0.0001 | 0.0003 | 0.0004 | 0.0002 |
Sequencing Data
| R1 | R2 | |||||||||
|---|---|---|---|---|---|---|---|---|---|---|
| G1 Post-START | S/G2 | Metaphase | Anaphase | Telophase | G1 Post-START | S/G2 | Metaphase | Anaphase | Telophase | |
| Gene Expression | 10.8513 | 7.1477 | 15.1539 | 10.4673 | 12.5882 | 12.5577 | 17.035 | 14.6332 | 17.2773 | 14.4531 |
| Translational Efficiency | 1.3605 | 2.4978 | 0.9319 | 2.6503 | 1.6838 | 2.1685 | 1.7059 | 2.232 | 2.0096 | 2.0582 |
Hit Data
| Dataset | Hit |
|---|---|
| Protein Concentration | ✘ |
| Protein Localization | ✘ |
| Gene Expression | ✘ |
| Translational Efficiency | ✘ |
Endocytosis
| Temp | Actin Patch (Sac6-tdTomato) | Cortical Patch (Sla1-GFP) | Late Endosome (Snf7-GFP) | Vacuole (Vph1-GFP) |
|---|---|---|---|---|
| 37℃ | ||||
| RT |
Cell Cycle Omics
CYCLoPs (Sol1-GFP)
| Gene / Allele | Actin Patch (Sac6-tdTomato) | Cortical Patch (Sla1-GFP) | Late Endosome (Snf7-GFP) | Vacuole (Sac6-tdTomato) |
|---|
| Gene | Images |
|---|
| Gene | Images |
|---|
Images are not yet available
Images are not yet available